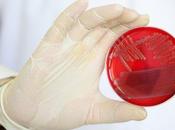
Ottawa accusé museler scientifiques sur-contrôler l'information

Monde — Vancouver
Monde — Vancouver
-
Yuketen for inventory items – maine guide shoe crepe

Inventory Items propose une fois de plus une version originale de la fameuse Main Guide Shoe de Yuketen. Conçue aux Etats-Unis en suède peanut et montée sur... Lire la suite
Le 04 avril 2012 par Glltn
NONE, NONE, NONE -
Sport d’hiver en lightpainting
Un beau travail du collectif russe Freezelight.ru qui date un peu puisqu’il s’agit d’un spot promotionnel pour les J.O. de Vancouver de 2010. Lire la suite
Le 03 avril 2012 par Fromrss
NONE -
Mission : Impossible 4 (Protocole fantôme)

Date de sortie 14 décembre 2011 (2h 13min) Réalisé par Brad Bird Avec Tom Cruise, Jeremy Renner, Simon Pegg plus Genre Action, Espionnage, Thriller Nationalité... Lire la suite
Le 03 avril 2012 par Mila1987
NONE, NONE, NONE -
Babe Rainbow feat. Grimes: Ambient 3 (Demo) - Stream Après avoir...

Played:83 [Flash 9 is required to listen to audio.] Babe Rainbow feat. Grimes: Ambient 3 (Demo) - Stream Après avoir vu les tracks de son projet Membrain (a... Lire la suite
Le 01 avril 2012 par La 3e Heure!
NONE, NONE -
Cinéma : Target (This means war)

Comédie américaine réalisé par McG avec Reese Witherspoon, Chris Pine, Tom Hardy, Til Schweiger, John Paul Ruttan, Chelsea Handler, Abigail Spencer, Angela... Lire la suite
Le 29 mars 2012 par Framboise32
NONE, NONE -
The Albertans lance l’EP The Hunter

The Albertans est un groupe qui s’est formé en 2008 à Vancouver et qui comprenait, à l’origine, 7 musiciens. Deux albums et plusieurs tournées nord-américaine... Lire la suite
Le 29 mars 2012 par Le Parallèle
NONE -
Chambres d’hotels

Vendredi 30 mars 2012 à 21h au théâtre Jean MaraisDans le cadre d’Escales en Val d’Oise, la ville de Saint-Gratien propose « Chambres d’Hôtels » de Valérie... Lire la suite
Le 24 mars 2012 par Qfqdmv
NONE -
De Stargate à Primeval

Depuis 2007, la série britannique Primeval (Nick Cutter et les portes du temps en version française) connait un certain succès à travers le monde, à tel point... Lire la suite
Le 19 mars 2012 par Kio
NONE, NONE, NONE -
Les Grizzlies sont à vendre ?
Les Memphis Grizzlies effectuent une belle saison en ce moment. Mais les jours dans le Tennessee sont peut-être comptés avant un éventuel départ pour la... Lire la suite
Le 17 mars 2012 par Insidebasket
NONE, NONE -
The Lazy MK’s – You Don’t Have To Go Home With Him

En plus d’avoir lancé son nouveau projet hip hop intitulé Vaults cette semaine, Michael Dawson, membre du groupe Library Voices de Régina, nous montre une... Lire la suite
Le 17 mars 2012 par Le Parallèle
NONE -
Woodson : la fin du phénomène Lin ?
Mike Woodson est le nouveau coach des Knicks au grand désarroi de Jeremy Lin qui ne va pas pouvoir autant se montrer qu'à l'époque de Mike D'Antoni. Mike Woodso... Lire la suite
Le 16 mars 2012 par Insidebasket
NONE, NONE -
Concert de Simple Plan à Rome

 ses débuts, le hardcore américain s’est développé dans différentes zones du pays. La Californie a été un des centres principaux au début des années... Lire la suite
Le 16 mars 2012 par Cardigan
NONE, NONE, NONE, NONE, NONE -
Quand un enfant chauffe tout un stade...
Si on aime se déplacer dans les stades pour soutenir nos équipes préférées c'est pour l'ambiance, le show et la ferveur de toute une foule... Lire la suite
Le 15 mars 2012 par Annesolubv
NONE -
Travailler dans une piquerie

Dominic Desmarais Dossiers Drogue, Site d’injections superviséesAu tournant des années 1980, Pierre, grand consommateur de drogues dures, se fait offrir par un... Lire la suite
Le 15 mars 2012 par Raymondviger
NONE, NONE, NONE -
Sonreal – I Tried

Previous : Sonreal – Celebrate (Remix)Previous : Sonreal – Day in the lifeOn avait deja parlé de ce jeune MC originaire de Vancouver lors de la sortie de «... Lire la suite
Le 14 mars 2012 par Unionstreet
NONE -
Lancement du 3ième Album de Maxime Robin – D.I.Y. SWAG 5 à 7 – Entrée Libre –...

Une dose « swaggalicieuse » de « vas-y, fais-le »! D.I.Y. swag, le nouvel album de Maxime Robin sortira le 20 février prochain sur l’étiquette de disque de... Lire la suite
Le 09 mars 2012 par Quoi Faire Au Québec | Exoquébec.com
NONE, NONE, NONE -
Un nouvel album en mai pour Brasstronaut

Le groupe Brasstronaut lancera un nouvel album intitulé Mean Sun le 15 mai 2012 sur l’étiquette de disque Unfamiliar Records. C’est en 2010 qu’on a découvert... Lire la suite
Le 09 mars 2012 par Le Parallèle
NONE -
Une ville économise 50,000 pages par année grace au iPad

Depuis Janvier dernier, la ville de Vancouver, Washington au États-Unis on adopté le iPad pour économiser sur le papier. Lors des conseils de ville, la... Lire la suite
Le 03 mars 2012 par Mac Québec
NONE -
La Permanence des objets

La musique couverte sur ce blogue originant souvent d’outre-atlantique ou de chez nos voisins du sud, les occasions d’annoncer un concert particulier à... Lire la suite
Le 03 mars 2012 par Georgesdimitrov
NONE, NONE, NONE -
La radio, c’est l’écriture

La radio a inventé depuis peu ce jeu étrange qui se nomme le téléchargement qui permet la baladodiffusion. Et cela change tout. Chacun est libre de... Lire la suite
Le 02 mars 2012 par Memoiredeurope
NONE, NONE, NONE, NONE, NONE, NONE -
Création Labiche : "La Main leste" suivie de "Mon Isménie!"
Après Paris, la compagnie de théâtre 7e Acte présente pour la première fois en région toulousaine deux pièces -"La Main leste" suivie de "Mon Isménie !"- écrite... Lire la suite
Le 02 mars 2012 par Toulouseweb
NONE -
Kathleen Edwards - Hannah Georgas à l'Ancienne Belgique ( Club), Bruxelles, le...

A 19h50' , l'AB club est anormalement désert, en vain tu cherches Photoman JP, lui qui habituellement fait l'ouverture des portes. Lire la suite
Le 01 mars 2012 par Concerts-Review
NONE, NONE, NONE -
Éditions de nouvelles (et d'anciennes)

Un court billet pour mentionner quatre textes récemment édités/réédités et disponibles en ligne.Le premier est une nouvelle épistolaire intitulée Hôtel Hilton,... Lire la suite
Le 29 février 2012 par Espritvagabond
NONE -
Detachment de Tony Kaye

Detachment n'est pas un film de plus sur le difficile exercice du métier d'enseignant.Certes, Adrien Brody campe le rôle d'un prof dans un établissement où les... Lire la suite
Le 27 février 2012 par A Bride Abattue
NONE, NONE -
Hôtel Hilton 11 février - Notes - 22 février 2012
Hôtel Hilton, 11 février - une nouvelle en neuf épisodes--Notes - Retour sur une nouvelle dont le futur se déroule maintenant dans le passé. Lire la suite
Le 26 février 2012 par Espritvagabond
-
Québec, 11 février 2011

Hôtel Hilton, 11 février - une nouvelle en neuf épisodes--Québec, 11 février 2011Chère Suzie,Eh bien, cette fois-ci, c’est pour de vrai. Je séjourne bien au... Lire la suite
Le 26 février 2012 par Espritvagabond
-
Munich, 11 février 2010

Hôtel Hilton, 11 février - une nouvelle en neuf épisodes--Munich, 11 février 2010Chère Suzie,Encore un emprunt de papier à l’hôtel, le Hilton de Munich, cette... Lire la suite
Le 26 février 2012 par Espritvagabond
-
Lloa, 11 février 2008

Hôtel Hilton, 11 février - une nouvelle en neuf épisodes--Lloa, 11 février 2008Chère Suzie,Pour respecter ce qui est devenu une tradition personnelle, je suis... Lire la suite
Le 26 février 2012 par Espritvagabond
-
Edimbourg, 11 février 2005

Hôtel Hilton, 11 février - une nouvelle en neuf épisodes--Edimbourg, 11 février 2005Chère Suzie,C’est un peu étrange de me retrouver dans un Hilton à t’écrire... Lire la suite
Le 26 février 2012 par Espritvagabond
-
Mon Plan d'Action Pour jeunes Sorcières Très Amoureuses de Mélanie Lafrenière

Disponible en ebook sur amazon ou ICIou en version papier auprès de l'auteurPrésentation:Elles’appelle Anségisèle Von Wienenberg, alias Gigi. Lire la suite
Le 24 février 2012 par Phooka
NONE, NONE -
Sonreal – Day in the life

Sonreal , jeune canadien qu’on avait découvert avec Kayo et Quake dans le morceau « Go hard » en mai dernier . Depuis le petit a fait du chemin . Lire la suite
Le 23 février 2012 par Unionstreet
NONE -
Jason Lamy Chappuis plus fort que Jason Statham

Pour beaucoup, Jason Lamy-Chappuis est né un soir de février 2010 (décalage horaire oblige) à Vancouver. La France découvrait ce jeune homme qui venait, 18 ans... Lire la suite
Le 23 février 2012 par Wtfru
NONE -
Les chariots de l’enfer.

Aujourd’hui sur twitter Je suis tombé sur une perle, un documentaire appelé les “Chariots de l’enfer”. Un documentaire de 60 minutes sur des SDF qui dévalent le... Lire la suite
Le 22 février 2012 par Jéremie Eloy
NONE, NONE, NONE -
PERTE de POIDS: Quand le corps ne répond plus aux régimes – AAAS

La perte de poids ralentit-elle alors que le corps s'adapte aux régimes ? Un régime amaigrissant devrait prendre en compte les changements dans le métabolisme... Lire la suite
Le 22 février 2012 par Santelog
NONE -
Grimes ‘ Visions

Quelle pochette ! Un groupe de métal scandinave aurait très bien pu l’utiliser sans que cela ne choque personne ! Sans aller jusqu’à dire que c’est un pari... Lire la suite
Le 22 février 2012 par Heepro Music
NONE, NONE -
Cybercriminalité...
Les 10 villes canadiennes les plus exposées à la cybercriminalité Un classement établi lors d'une étude menée par deux firmes privées révèle que ce sont les... Lire la suite
Le 22 février 2012 par Lawrence Desrosiers
-
BIOTECHNOLOGIE: Un hamburger-éprouvette à partir de cellules souches? – AAAS

En pleine épidémie « de Schmallenberg » et au-delà, en pleine crise alimentaire, cette recherche pourrait trouver sa raison d'être. Lire la suite
Le 22 février 2012 par Santelog
NONE -
Le speed-riding, nouvelle discipline entre le ski et le parapente

Depuis une dizaine d'années, le sport en montagne évolue constamment. Après le retour à la mode de disciplines oubliées comme le télémark ou le monoski, certain... Lire la suite
Le 21 février 2012 par Gigistudio
NONE -
Jean-Claude Caër, En route pour Haida Gwaii

Jean-Claude Caër, En route pour Haida Gwaii, Obsidiane, 2011. Topique : Voyage et récits de voyage Source LE CHANT SALISH DE JEAN-CLAUDE CAËR Partir. Partir... Lire la suite
Le 20 février 2012 par Angèle Paoli
NONE, NONE -
L’Impact débute sa saison bientôt !
Dès le 10 mars, l’Impact de Montréal disputera son premier match dans Major League Soccer. L’équipe s’est assurée des services du défenseur italien Matteo... Lire la suite
Le 20 février 2012 par Jsdum
NONE -
Ottawa accusé de museler ses scientifiques et de sur-contrôler l'information
Dans un colloque réunissant à Vancouver des scientifiques et des journalistes de partout dans le monde, le gouvernement fédéral a été accusé hier de museler... Lire la suite
Le 19 février 2012 par Plusnet
NONE, NONE -
Les SCIENTIFIQUES Européens mettent la science avant la politique – Congrès...

Des scientifiques européens, spécialistes de domaines aussi divers que l'énergie nucléaire, la génétique ou encore la lutte contre le tabagisme s'exprimaient, l... Lire la suite
Le 19 février 2012 par Santelog
NONE -
Critique Ciné : Le Territoire des Loups, froid intense...

Le Territoire des Loups // De Joe Carnahan. Avec Liam Neeson, Dallas Roberts et Frank Grillo. J'avais entendu parlé de ce film lors de sa sortie américaine il... Lire la suite
Le 18 février 2012 par Delromainzika
NONE, NONE -
Chemin d'éveil par Claudette Vidal

Jean-Louis Accarias publie un livre de Claudette Vidal, qui est vraiment très bien. CLAUDETTE VIDAL CHEMIN D’ÉVEIL Un guide contemporain d’éveil... Lire la suite
Le 18 février 2012 par Joseleroy
NONE, NONE -
[Critique] UNDERWORLD - NOUVELLE ERE (Underworld : Awakening) de Måns Mårlind &...
![[Critique] UNDERWORLD NOUVELLE (Underworld Awakening) Måns Mårlind Björn Stein](https://media2.paperblog.fr/i/532/5321241/critique-underworld-nouvelle-ere-underworld-a-L-D37iJa-175x130.jpeg)
On pensait en avoir terminé avec la saga Underworld, il y a 3 ans, avec l’épisode moyenâgeux de Tatopoulos. Avec la combi en cuir de Kate Beckinsale aussi, qui... Lire la suite
Le 17 février 2012 par Celine_diane
NONE, NONE -
Stan Sakai : Angoulême y Animé Los Angeles

Un petit billet pour signaler que Stan a publié sur son livejournal un CR en photo de son séjour d’une semaine en France lors du festival d’Angoulême (où il... Lire la suite
Le 14 février 2012 par Ladrevert
-
Critiques Séries : Alcatraz. Saison 1. Episode 6. Paxton Petty.

Alcatraz // Saison 1. Episode 6. Paxton Petty. Après une horde d'épisodes assez redondants, Alcatraz montre pour une fois que la formule de la série peut être... Lire la suite
Le 14 février 2012 par Delromainzika
NONE, NONE -
Les Detroit Red Wings proche du record

La vague de froid qui s’est abattue sur notre pays ne doit pas nous faire oublier que la NHL aussi se joue sur la glace. so-Sport vous propose, en plus de... Lire la suite
Le 12 février 2012 par Ptimek
NONE -
Coupe Davis : Monfils remplacé par Benneteau
L’édition 2012 de la Coupe Davis commence aujourd’hui à Vancouver pour des Français qui vont affronter, pour leur premier tour, l’équipe du Canada. Lire la suite
Le 10 février 2012 par Ptimek
NONE -
Best of des « Chinatown » du monde

Vous avez raté le nouvel an chinois ? Moi aussi ! Prenons donc bonnes notes pour l’année prochaine avec ce Best of des « Chinatown » du monde. 1. Lire la suite
Le 08 février 2012 par Vinivi
NONE, NONE -
Peut-être Yann Moix n'aime-t-il pas lire...

Yann Moix se fait encore remarquer. Il adore ça. Et pratique volontiers l'excès pour être certain de s'offrir un bref moment de gloire. Lire la suite
Le 08 février 2012 par Pmalgachie
NONE, NONE -
Faire fi de ceux qui savent

À la Bourse, mieux vaut faire fi de ceux qui savent (ou qui pensent savoir). Pour investir, une compréhension générale de l’économie, des tendances du marché e... Lire la suite
Le 08 février 2012 par Fabien Major
NONE, NONE, NONE -
Les Miettes du Mercredi: Jake Ballard, Mario Manningham et plus...

Ballard gravement blessé, Manningham sera un agent libre convoité et plus... -Le TE Jake Ballard s'est déchiré l'ACL du genou gauche lors du Super Bowl et... Lire la suite
Le 08 février 2012 par Sixverges
NONE, NONE -
Manifestations pacifistes dans plus de 80 villes, contre une possible guerre ave...

Plusieurs centaines de personnes ont manifesté samedi dans 80 villes américaines et canadiennes à l'occasion d'une «journée d'action de masse» convoquée par... Lire la suite
Le 05 février 2012 par Plusnet
NONE, NONE -
La fille qui se moquait des conventions

GRIMES VISIONS Quelque part dans un appartement à Montréal, au détour d'une rue, une jeune femme de 23 ans répondant au nom de Grimes fait la musique comme... Lire la suite
Le 04 février 2012 par Teazine
NONE, NONE, NONE -
Journal de bord : sur le tournage d'"Alcatraz" [Jour 3]

Jeudi 2 Février – Day Three En ce deuxième et déjà dernier jour de visite du tournage d’Alcatraz, le maître-mot aura été « patience ». Lire la suite
Le 03 février 2012 par Lulla
NONE, NONE, NONE -
Coup de coeur : Panty by Post, une culotte à domicile !

Je suis trop contente les Bees, ce matin j'ai reçu par la poste un très joli et très coquin colis. Dans un petit paquet rectangulaire, enroulée dans un papier d... Lire la suite
Le 03 février 2012 par Gossipcarobe
NONE, NONE, NONE -
Journal de bord : sur le tournage d'"Alcatraz" [Jour 2]

Mercredi 1er Février – Day Two La première chose que je me suis dit en me réveillant ce matin très tôt, après avoir été surpris par un beau rayon de soleil pas... Lire la suite
Le 02 février 2012 par Lulla
NONE, NONE, NONE -
Football e lingerie

Les féministe vont surement écouter ça! (la gamique) Alors que tous les yeux sont tournés vers le Super Bowl XLVI à Indianapolis, le désormais célèbre Lingerie... Lire la suite
Le 01 février 2012 par Cheaplabel
NONE -
Journal de bord : sur le tournage d'"Alcatraz"

Mardi 31 Janvier - Day One Il y a des opportunités qui ne se refusent pas. Celle de partir trois jours au Canada à Vancouver, sur le tournage de la nouvelle... Lire la suite
Le 01 février 2012 par Lulla
NONE, NONE, NONE -
Des groupes sociaux se mobilisent contre le Service Canadien de Renseignement...

Près de 80 groupes sociaux canadiens ont lancé dimanche une campagne de «non-coopération» avec le Service canadien de renseignement et de sécurité (SCRS). Lire la suite
Le 30 janvier 2012 par Plusnet
NONE, NONE -
Le Crépuscule des dieux de Richard Wagner par Robert Lepage : une lueur sobre...

28 janvier 2012 (No 2012- 04) Photographie : Daniel Turp, 2012 Les opéraphiles de New York ont rempli les 3 995 places du Metropolitan Opera House pour... Lire la suite
Le 28 janvier 2012 par Turp
NONE, NONE, NONE -
Le chiffre du jour : 55 $
Les résultats de cette étude montrent que Montréal assure un leadership certain en matière de dépenses culturelles (dépenses de fonctionnement sans les... Lire la suite
Le 27 janvier 2012 par Magazinenagg
NONE, NONE, NONE -
paul hellyer-exopolitique

Paul Hellyer L'ancien Ministre Canadien de la Défense et Député du temps de Pierre Trudeau a rejoint les rangs de trois organisations non gouvernementales pour... Lire la suite
Le 22 janvier 2012 par Cheaplabel
NONE -
Critiques Séries : Les Experts : Manhattan. Saison 8. Episode 3.

Les Experts : Manhattan // Saison 8. Episode 3. Cavallino Rampante. Après Cassidy Freeman, puis Aly Michalka, c'est maintenant au tour de Coutney Ford... Lire la suite
Le 16 janvier 2012 par Delromainzika
NONE, NONE -
Métaux sous-marins: attention, la pêche est ouverte

Dès la fin de 2013, une petite société minière canadienne pourrait lancer la première exploitation sous-marine de minéraux métalliques, en... Lire la suite
Le 14 janvier 2012 par Plusnet
NONE, NONE -
Et sinon, ce week-end y'a les Golden Globes

Mes papillotes de brochet, comme chaque année, je m'apprête à me repaître des Golden Globes et de leur parfum suave d'amuse-bouche des Oscars. Lire la suite
Le 13 janvier 2012 par Vinsh
NONE -
Jim Corcoran : « C’est par les associations qu’on évolue »

Il est assez inhabituel, pour un anglophone pure souche, de faire carrière dans la langue de Molière. Et a fortiori, de devenir l’un des plus grands chantres... Lire la suite
Le 12 janvier 2012 par Titus
NONE, NONE, NONE, NONE -
Julian Feoli un Argo's

Julian Feoli aura la chance de poursuivre sa carrière avec Toronto dans la CFL Julian Feoli a paraphé une entente de 3 ans avec les Argonauts deToronto. Julian ... Lire la suite
Le 12 janvier 2012 par Raton66
NONE, NONE, NONE -
Un album et une tournée solo pour John K. Samson

John K. Samson, leader du groupe The Weakerthans, lancera son premier album solo intitulé « Provincial » le 24 janvier prochain. Lire la suite
Le 11 janvier 2012 par Le Parallèle
NONE -
Grimes ‘ Genesis

Alors que l’album Visions ne sortira qu’en mars, il sera sans doute sur Internet avant puisqu’il sortira en février au Canada et aux Etats-Unis. Lire la suite
Le 11 janvier 2012 par Heepro Music
NONE, NONE -
[ciné] Mission impossible : Protocole fantôme
![[ciné] Mission impossible Protocole fantôme](https://media4.paperblog.fr/i/520/5206764/cine-mission-impossible-protocole-fantome-L-Ch1l0e-175x130.png)
3,6/5 Pour ses premières prises de vues réelles (après le chef-d’œuvre les Indestructibles et le très bon Ratatouille), Brad Bird s’est vu confier un budget... Lire la suite
Le 08 janvier 2012 par Vance
NONE -
Les poules de mon grand-père (2)

«Je suis persuadé que beaucoup d'enfants ignorent d'où viennent les oeufs»- François Croteau, maire de l'arrondissementRosemont-La Petite-Patrie(propos rapporté... Lire la suite
Le 08 janvier 2012 par Espritvagabond
-
La METHamphétamine associée au risque de suicide – Drug and Alcohol Dependence

Cette étude, l'une des plus grandes cohortes américaines sur le sujet, démontre que des efforts de prévention du suicide doivent être un volet clé des programme... Lire la suite
Le 08 janvier 2012 par Santelog
NONE -
En intimité avec Tegan and Sara

Les plus belles jumelles au monde sont de retour ! Je vais évidemment vous parler des soeurs Tegan and Sara ! Nous avons de la chance, elles nous reviennent en... Lire la suite
Le 07 janvier 2012 par Gangansurleweb
NONE -
Les poules de mon grand-père (1)

"Évitez les OGM. Compostez. Réduisez votre consommation. Fermez les robinets. N’oubliez pas vos sacs réutilisables. Baissez votre thermostat. Achetez des... Lire la suite
Le 07 janvier 2012 par Espritvagabond
-
From the Vault : Story of Skinny Puppy (1/2)

L’histoire de Skinny Puppy pourrait être celle d’une banale rencontre, celle de cEvin Key, encore connu sous le nom de Kevin Crompton, alors claviériste du... Lire la suite
Le 07 janvier 2012 par Hartzine
NONE, NONE -
Triple anniversaire dans Stargate

Aujourd'hui, nous fêtons l'anniversaire de Joe Flanigan (45 ans) et de Paul McGillion (43 ans), deux acteurs emblématiques de la série Stargate Atlantis. Mais... Lire la suite
Le 05 janvier 2012 par Kio
NONE, NONE, NONE -
Café de Flore, un film qu’on aime ou pas

Je ne peux passer sous silence le film Café de Flore, que j’ai vu récemment. Il y a tellement de films insipides alors, lorsqu’on a la chance de croiser LE... Lire la suite
Le 05 janvier 2012 par Gintonhic
NONE, NONE -
Récapitulation de la saison 2011

Pour moi, faire de la photo à une telle température demeurera un moment inoubliable de cette saison 2011 ! Année après année le Rouge et Or nous a habitué à... Lire la suite
Le 02 janvier 2012 par Raton66
NONE, NONE, NONE -
Max Payne 3 : une image sinon rien

Comme beaucoup d'autres développeurs en ce moment, Rockstar Vancouver tient à souhaiter ses meilleurs vœux à la communauté de Max Payne 3. Lire la suite
Le 31 décembre 2011 par Axime
NONE, NONE, NONE -
Je craque pour Robbie Pyle et son Alfa Romeo Giulia Sprint GT de 1965

Il est design engineer .. Et parle de son ALfa Romeo comme d'une oeuvre d'art. Outre son auto qu'il a découvert à Vancouver (tout se passe de l'autre côté de... Lire la suite
Le 27 décembre 2011 par Frédérique Barteau
NONE, NONE -
Top Dix
Chaque fin d’année apporte son lot de Tope disse et bla bla bla… Loin de moi l'idée de paraitre condescendant et arrogant avec mes goûts musicaux, mon but est d... Lire la suite
Le 27 décembre 2011 par Munch
NONE, NONE -
2011 en onze petits morceaux

Choix difficile et très personnel de 10 11 titres qui ont fait 2011 pour moi. Hardu car j'ai beaucoup écouté de reprises cette année et que j'ai été passablemen... Lire la suite
Le 26 décembre 2011 par Milega
NONE, NONE -
25 Musiques de 2011

25 Décembre. Zavez aimé vos cadeaux? Zavez obtenu ce que vous souhaitiez? Zavez un certificat cadeau là où se vend de la zizik? Zavez reçu de l'argent pour... Lire la suite
Le 25 décembre 2011 par Hunterjones
NONE, NONE, NONE -
Vincent JAY, champion olympique de biathlon, répond à notre interview sur sa...

En pleine étape autrichienne de la coupe du Monde de biathlon, Vincent JAY, champion olympique de biathlon, a accepté de répondre à nos questions. Lire la suite
Le 21 décembre 2011 par Dietetique
NONE -
L’avenir du continent se joue chez ce géant africain

La population congolaise lutte depuis longtemps pour la fin de la corruption et le pillage des ressources Les dernières élections ne répondront pas aux attentes. Lire la suite
Le 21 décembre 2011 par Rm Communication
NONE -
L’Hollow Chair by Judson Beaumont

On a littéralement craqué pour ce fauteuil club ! Comme on dit… Les idées les plus géniales sont bien souvent les plus simples. Lire la suite
Le 20 décembre 2011 par Etv
NONE, NONE, NONE, NONE, NONE -
L’Hollow Chair by Judson Beaumont

Facebook Twitter On a littéralement craqué pour ce fauteuil club ! Comme on dit… Les idées les plus géniales sont bien souvent les plus simples. Lire la suite
Le 19 décembre 2011 par Etv
NONE, NONE -
Les 25 meilleurs albums de 2011 : les positions 25 à 21

Si le crash boursier de 1929 a précédé la grande dépression, les faux espoirs de 2010 ont été les préludes d’une grande désillusion. Lire la suite
Le 19 décembre 2011 par Feuavolonte
NONE, NONE -
30 souvenirs en guise de double anniversaire

J'avais déjà fait mention de l'événement sur ce blogue, mais comme c'est annuel comme célébration, je me permets de revenir cette année sur l'anniversaire de me... Lire la suite
Le 16 décembre 2011 par Espritvagabond
-
Sound Sculpture

Bonne nouvelle pour tous ceux qui s'intéressent à la sculpture sonore, le livre de John Grayson, "Sound Sculpture", publié à l'origine à Vancouver en 1975 par... Lire la suite
Le 16 décembre 2011 par Sonolor
NONE, NONE, NONE -
Joyeux anniversaire Michael!

Nous sommes le 15 décembre et il y a encore un anniversaire Stargate. En effet, Michael Shanks fête aujourd'hui ses 41 ans. De son vrai nom Michael Garrett... Lire la suite
Le 15 décembre 2011 par Kio
NONE, NONE, NONE -
Les 30800 places de stationnement de San Francisco équipées de NFC avec...

PayByPhone ajoute la technologie NFC au paiement par mobile des 30800 places de stationnement de San Francisco. PayByPhone leader des services de paiement par... Lire la suite
Le 15 décembre 2011 par Philippe Lerouge
NONE, NONE -
Breakdance:Une tournée internationale pour Lazy Legz

Luca Patuelli et le BreakdanceUne autre première page pour Lazy LegzEn 2007, Lazy Legz fait la page couverture du magazine Reflet de Société et nous parle de se... Lire la suite
Le 14 décembre 2011 par Raymond Viger
NONE, NONE -
Le chiffre du jour : 17 %
Montréal consacre 17% de son budget à financer une dette de près de 5 milliards $. La dette de Toronto est de 2 milliards $ et ne coûte que 2,5% du budget.... Lire la suite
Le 14 décembre 2011 par Magazinenagg
NONE, NONE, NONE -
« Dingue !! Les agences de notation ont viré Berlusconi et Papandréou pour fair...

Pour faire court et cerner les fameuses AGENCES DE NOTATIONSLes principales agences de notations sont à l’origine, toutes américaines comme Moody’s créé par Joh... Lire la suite
Le 13 décembre 2011 par Ghx62
NONE, NONE -
Quentin la palpite

Au point d'effusion des égouts: Un premier roman qui « arrache ». En vrille étincelante, entre Los Angeles et le bout de nulle part. Lire la suite
Le 12 décembre 2011 par Jlk
NONE, NONE -
Les indignés occupent conjointement les ports du Pacifique aux États-Unis et au...

Des anti-Wall Street se sont rassemblés lundi dans plusieurs ports américains et canadiens de la côte Pacifique, perturbant le trafic de marchandises sans... Lire la suite
Le 12 décembre 2011 par Plusnet
NONE, NONE -
Changement à prévoir chez le CH…?

Certaines rumeurs circulent comme de quoi que le match de ce soir contre Vancouver pourrait être le match qui va décider de l’avenir de Pierre Gauthier et de... Lire la suite
Le 08 décembre 2011 par Rdoyle
NONE, NONE
Afficher les articles
- Les plus lus